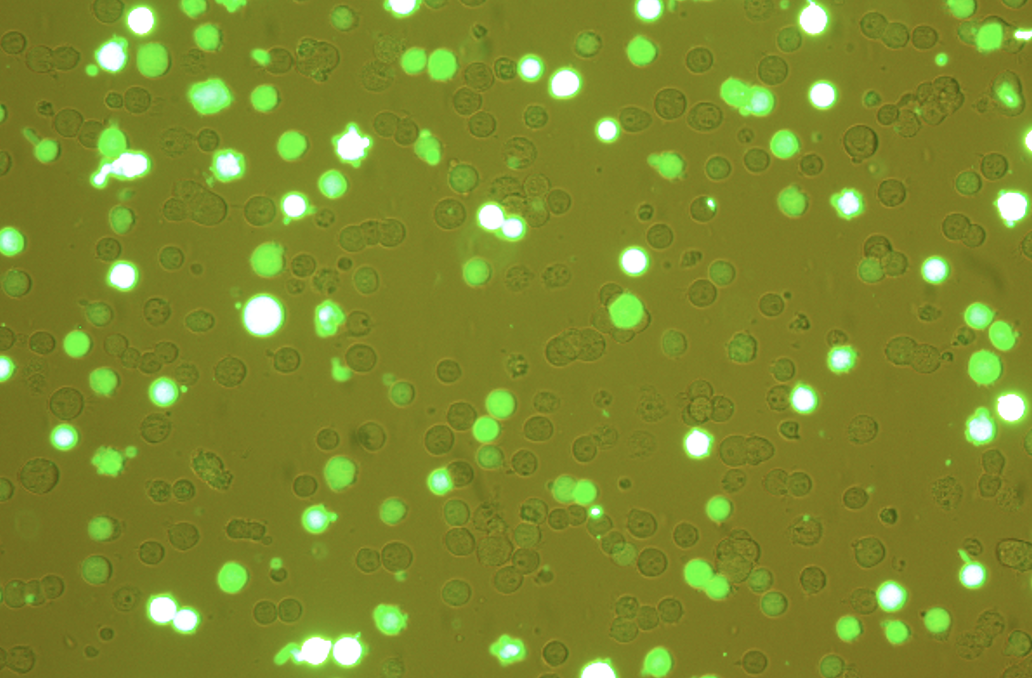
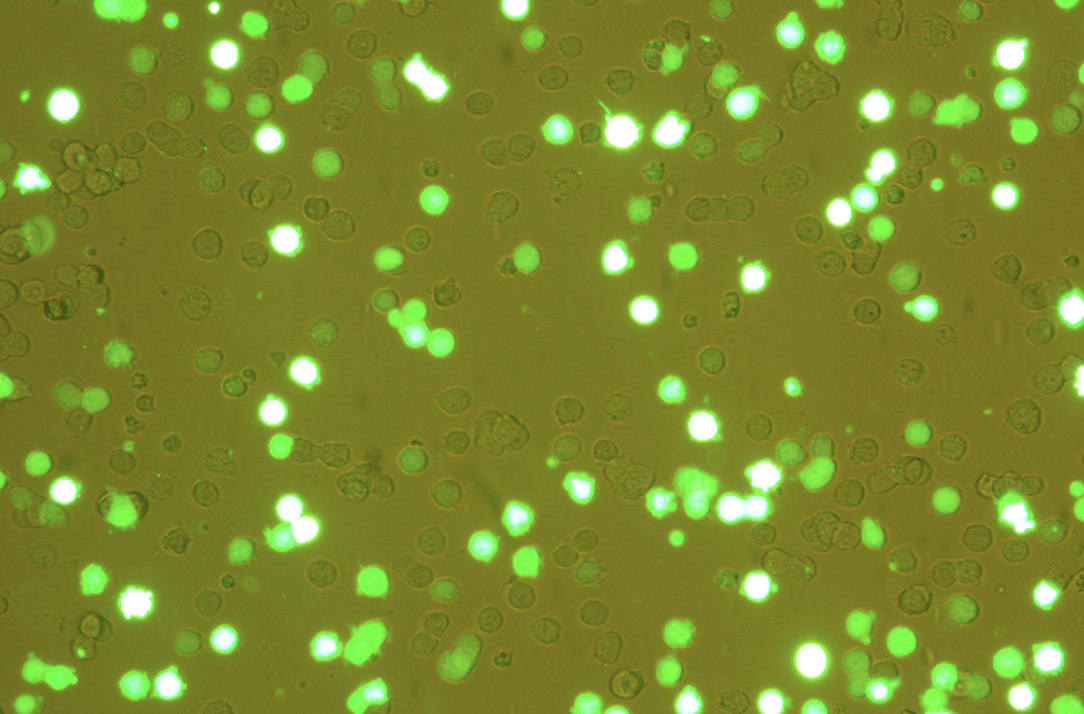
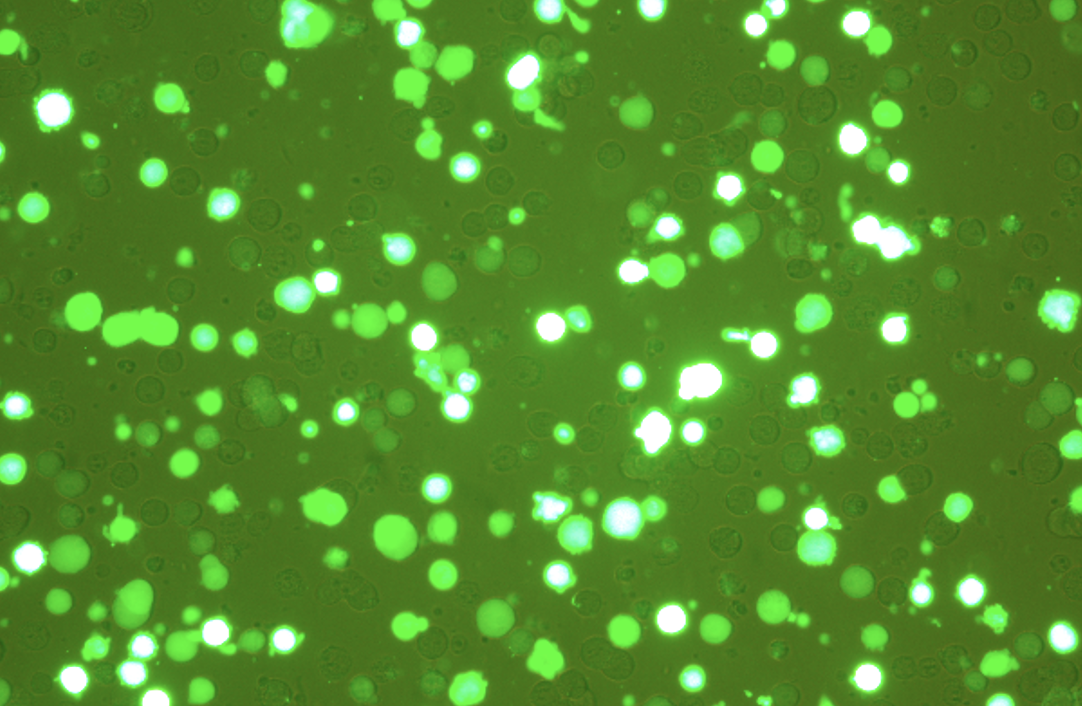
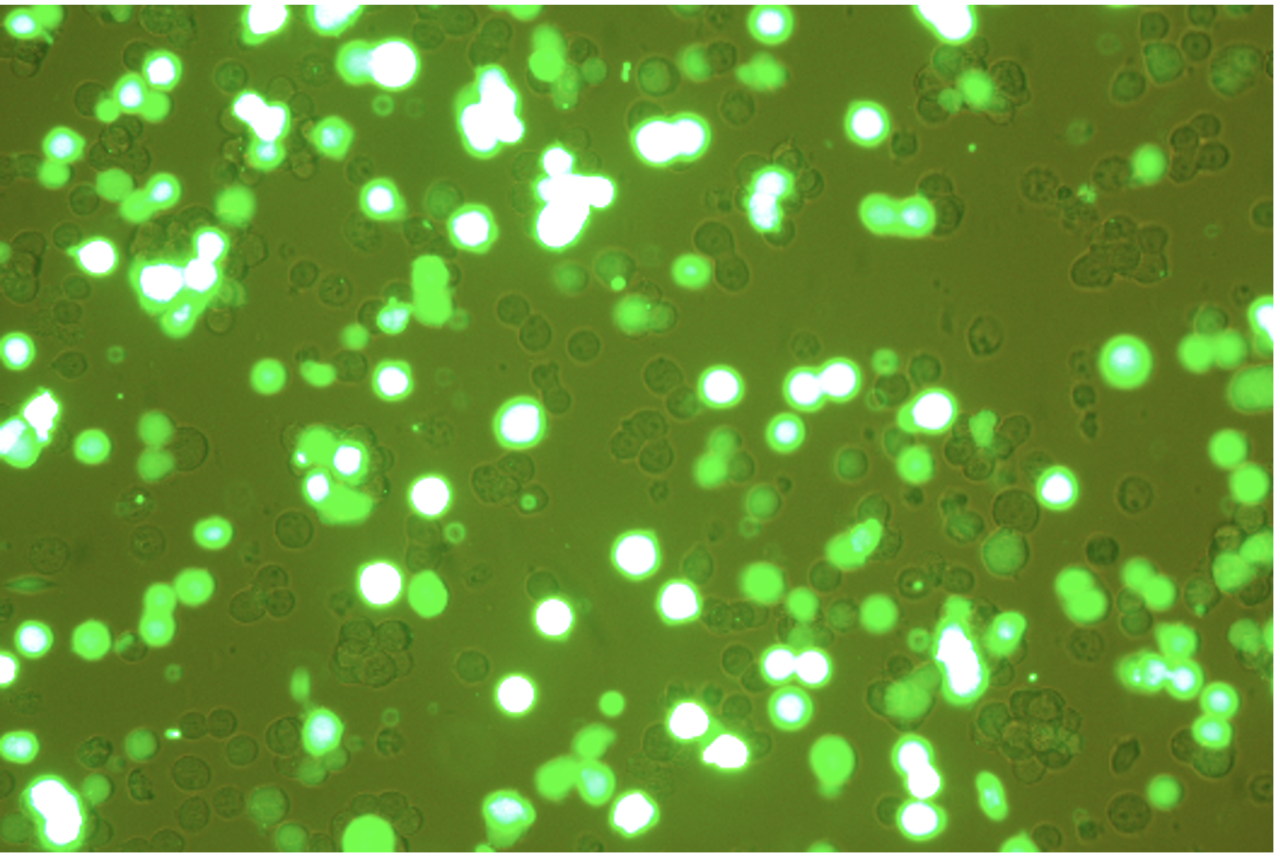
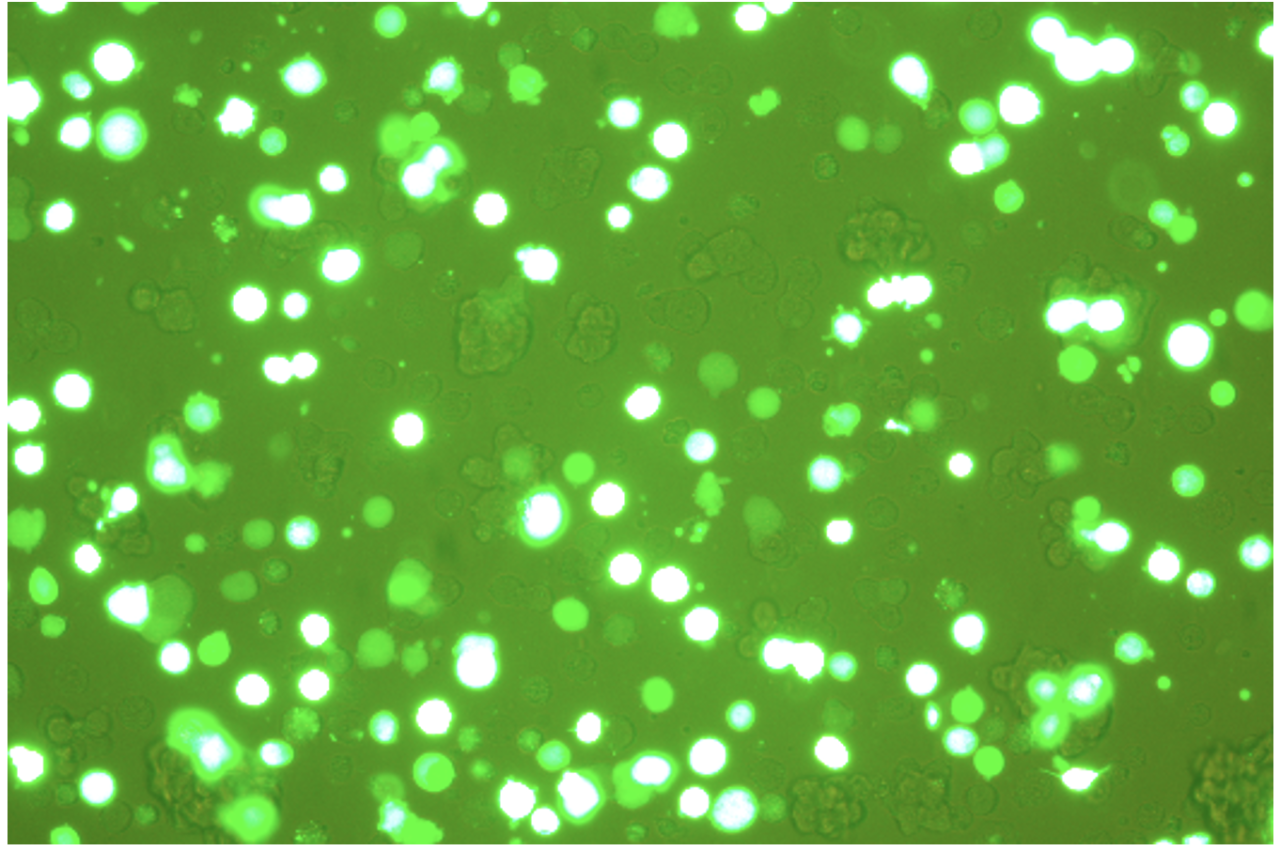

早期AAV(Adeno-associated virus,简称AAV — 腺相关病毒)产品的病毒载体培养方式多采用贴壁培养。但随着工艺的提升,悬浮培养能更好地满足生产工艺的放大升级,故此,由贴壁培养转向悬浮培养的293T细胞系成为了新型趋势。
本文分享一则新型HEK293细胞AAV包装工艺研究实例,主要基于乐纯生物LePhinix®EZG 台式生物反应器中Pro款型号,即:LePhinix®EZG Pro 台式生物反应器,通过自研的TinnBio自控软件实现对搭载玻璃罐的精准控制,实现AAV高表达滴度、高体积培养。

设备与工艺
培养参数
本研究采用乐纯生物集团旗下康晟生物自主研发的Wayne293®瞬转培养基,培养悬浮细胞Wayne® LVPro HEK293。
LePhinix®EZG Pro 台式生物反应器参数设置如下表1所示,接种前,需对玻璃罐进行保压测试及灭菌梳理,再加入Wayne293®瞬转培养基进行预培养,预培养参数参考表2。

表1.LePhinix®EZG Pro 台式生物反应器配置参数

表2.玻璃罐参数设置
培养小Tips
悬浮培养过程中,AAV转染需注意:
接种密度、转染细胞密度、转染时间;转染培养基;质粒比例、质粒总量、PEI与质粒比例;转染后收货时间等因素,这些变量因素是决定AAV产量高低的关键。
培养工艺
摇瓶阶段:
- 种子复苏后,每隔 48h 按照 0.5M 传代;
- 种子轻微聚团,可适当提高摇床转速或者采用带档板摇瓶培养;
- 一般建议细胞浓度达到2.5M~3.0M,且活率>95%进行转染;
转染阶段:
- 转染前检测细胞悬液中 Glc&Gln 含量,需调整悬液 Glc≥6g/L 和 Gln≥4mM;
- 转染试剂配置时,推荐质粒:PEI=1:3,且现配现用;
上罐阶段:
- 先接入终体积 80% 培养基,设置参数,空罐预培养 4h 以上;
- 按照 0.5M 接种进行操作;
- 每天无菌取样计数,待细胞浓度达到2.5M~3.0M,且活率>95%进行转染;
- 转染后每隔 24h 取样计数,流式或荧光拍照得出转染效率,留样 QPCR 等;
- 一般转染 72h 左右实验室测得GFP(目的基因)转染效率最高,最后进行 QPCR 病毒滴度测试;
- 准备下罐或继续培养,收集数据。
注:优化工艺阶段,可通过不同时间段留样对比目的基因的转染效率与滴度值波动的相关性,选取最优工艺,进行后续生产。
数据分析

表3.1L(200rpm)某批次培养数据
注:day05 72h 测 QPCR 为 8.41E+11copies/ml。

图1.转染24h荧光照片
图2.转染48h荧光照片

图3.转染72h荧光照片

表4.1L(220rpm)某批次培养数据

图4.转染24h荧光照片
图5.转染48h荧光照片
图6.转染72h荧光照片


表5.5L(80rpm)某批次培养数据
注:day05 72h 测 QPCR 为 1.18E+12copies/ml。

图8 转染24h荧光照片
图9 转染48h荧光照片
图10 转染72h荧光照片
结论
通过以上几批玻璃罐内包装 AVV 实验数据可知,转染第三天 AVV 滴度稳定表达 8~9E+11copies/ml,其中 5L 培养体积最高达到 1.18E+12copies/ml。

对比台式反应器控制 200rpm 和 220rpm 批间差异不大,细胞生长过程一致,数据具有高度重合性,说明台式反应器控制精准,各部件协作调控功能稳定。
综上,LePhinix®EZG PRO台式反应器可实现温度,pH,溶氧等关键工艺参数的精准控制,搭配Wayne293® 瞬转培养基,可更好的实现293细胞AAV包装工艺优化,提升293细胞的生长效果和达到更高的病毒产量。
More
LePhinix®EZG 台式生物反应器全谱系家族三种款式,满足多种功能选择
扫描二维码获取产品资料
更可申领样机体验

乐纯生物集团产品专员
关于Wayne293® 瞬转培养基
Wayne293® 瞬转培养基是一款针对人类胚胎肾细胞 293 (HEK293) 和其衍生细胞系所研发的无血清、无动物成分培养基,适用于 HEK293 系列细胞悬浮培养、化学转染及瞬时转染,具有高密度增殖、高效率转染和高产量表达的独特优势。


EN